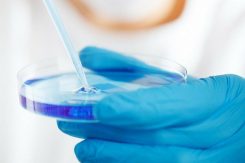

Quieres contar historias a través de imágenes, pero no sabes cómo empezar. El cine es muy amplio, ¿tengo que irme a estudiar fuera? ¿Tengo que pagar cursos costosos? ¿Debo comprar equipo profesional?
¿Qué es un mockup y cómo crear uno para tu proyecto?
En el mundo del diseño gráfico seguramente has escuchado la palabra Mockup, sin embargo, no muchos conocen su definición. El día de hoy daremos respuesta a la gran pregunta de ¿Qué es un Mockup y para qué sirve?
Relajar la mente: un ejercicio de paciencia
Estrés, preocupaciones, asuntos rutinarios, afanes diarios, estilo de vida ocupados… ¿Quién se esfuerza todo el día para relajarse y sentirse impotente? Para muchas personas, relajar la mente no es tan fácil como relajar el cuerpo. Sin embargo, la práctica perseverante es el único camino para lograrlo. Mantener la calma física y mentalmente puede ser la clave de nuestra felicidad. ¿Necesitas algunas habilidades para aprender a relajarte? Sigue leyendo. Además, recuerda que puedes certificarte para trabajar profesionalmente, con la Certificación en Psicología Holística o el Curso de Mindfulness.
¿Cuáles son los géneros cinematográficos más importantes?
El cine es mundo lleno de posibilidades en donde la creatividad, la pasión por el arte y el talento se suman para hacer creaciones para todo tipo de público, para todos los gustos. Cada creación puede encasillarse en un género cinematográfico determinado… de hecho, existen muchos de ellos.
El Proyecto WELCOME: cómo la tecnología puede ayudar en la inserción de las personas inmigrantes
El Grupo Método se complace en anunciar uno de los acontecimientos más importantes para la comunidad estudiantil. Se trata de la presentación del Proyecto WELCOME en el marco de dos de los eventos internacionales más reconocidos a nivel académico y profesional.
La revolución de los ejercicios HIIT en el mundo del fitness
Las calorías quemadas en unos minutos son más calorías quemadas que una hora entera de entrenamiento. Sí, aunque es increíble, es posible. Los ejercicios HIIT es una forma mágica de lograr este objetivo. Por supuesto, estamos hablando de un entrenamiento de corta duración, pero de alta intensidad, hay que hacer todo lo posible.
La educación conductual, el pilar principal del Proyecto Jarque

Olga Jarque Gago recibió el galardón “Dilo todo contra el bullying” en reconocimiento al proyecto Jarque. ©O. J
El aprendizaje de un individuo comienza desde una edad muy temprana. En la etapa escolar se aplican diversas técnicas cuyo propósito es promover el aprendizaje integral y el desarrollo de nuevas habilidades en el niño. Por ejemplo, conocimientos musicales básicos, el aprendizaje de las letras, números y colores; conceptos prematemáticos y lingüísticos, entre otros.
Aprende a decir “no” sin sentir culpa
Hoy en día, uno de los problemas de conducta y comportamiento que tal vez se ha generalizado más es la imposibilidad de una persona para saber decir que no ante distintas situaciones que lo pongan a prueba.
¿Cuántos tipos de innovación hay?
Las demandas del mercado laboral exigen estar al tanto de los talentos creativos e innovadores. Por su importancia, el Día Mundial de la Creatividad y la Innovación se celebra el 21 de abril de cada año, con el propósito de promover el pensamiento creativo. Esta fecha coincide con el nacimiento de Leonardo Da Vinci, una de las figuras más influyentes y creativas de la historia de la humanidad. En honor a este día, IEBS Business School, escuela de negocios digital líder en formación online, ha preparado el siguiente artículo para explicar y ahondar en la innovación y los diferentes tipos que existen.
Hyaluron pen: una técnica menos invasiva para tratar los labios
El cuidado personal y estético es uno de los campos en los que, a través de la tecnología, más avances se han producido en los últimos años. Esto ha contribuido a que los tratamientos se puedan realizar de mejor manera y, por tanto, los resultados sean más satisfactorios para todas las personas involucradas. En ese sentido, ESSAE ESCUELA SUPERIOR ofrece para quienes estén interesados en este universo un nuevo curso dentro de su programa de Medicina Estética, el Curso Técnico en Hyaluron Pen, para formar a distintos profesionales dentro de la voluminización labial sin el uso de agujas.
MIT- LAB forma a expertos en Microbiología
¿Te interesa la Microbiología? MITLAB cuenta con formación técnica y especializada en el área, y lo puedes descubrir en este post.
ISO/IEC 27701:2019: la extensión de la norma ISO/IEC 27001
Los avances en la tecnología día a día han traído grandes cambios a nivel organizacional. Con la implementación de nuevos procesos empresariales, los datos se han convertido en uno de los recursos fundamentales en la actualidad.
Culmina la primera edición del Máster Universitario en Química en la Frontera con la Biología y la Ciencia de Materiales
Este mes, los alumnos miembros de la primera promoción del Máster Universitario en Química en la Frontera con la Biología y la Ciencia de Materiales (CHEMBIO&MAT) realizaron la defensa de su Trabajo Final de Máster. En esta ocasión, los estudiantes tuvieron la posibilidad de exponer ante el tribunal evaluador las investigaciones que han llevado a cabo a lo largo del curso. Supervisados por científicos de reconocido prestigio, los estudiantes eligieron algunos temas como el diseño de nuevos precursores para el nanografeno poroso y el desarrollo de materiales biomiméticos. Juan R. Granja, coordinador del programa señala «Los alumnos han mostrado un gran interés por aprender, la calidad de los trabajos presentados y su exposición ha sido excepcional».
Formación online: la mejor alternativa para estudiantes y empresas
Con la llegada y evolución constante de las nuevas tecnologías, uno de los sectores que más cambios ha tenido es el de la educación. Y es que precisamente, gracias a las ventajas que trae la tecnología, hoy en día la educación es más accesible para todos… ya no existen barreras de tiempo ni espacio que impidan acceder a programas educativos de calidad superior.
Sondas: cuántos tipos hay y para qué se usan
Dentro del universo sanitario se suele hablar con frecuencia sobre las sondas. Sus variantes, entre otras cuestiones, son comunes dentro del ámbito médico pero fuera de el puede haber distintas dudas. Si bien una sonda, en líneas generales, es un tubo de plástico que se introduce en el cuerpo por determinadas razones, hay distintos fines y utilidades sobre las que se profundizará a continuación, con el objetivo de aclarar dudas en este aspecto.
La SGS le ha otorgado el certificado de calidad ServiCert a la Universidad Internacional de Valencia – VIU
El día de hoy, la Universidad Internacional de Valencia – VIU se complace en anunciar una noticia muy positiva para toda su comunidad: la SGS, uno de los organismos de certificación independiente más importantes a nivel internacional, le ha otorgado a la universidad la Certificación de Calidad del Servicio de Enseñanza Universitario Online.
Este reconocimiento fue realizado oficialmente en la ceremonia de premiación, un evento que contó con la presencia de Eva María Giner, rectora de la Universidad Internacional Valencia – VIU; Mónica Rodríguez Gascó, directora de calidad de la universidad; y Juan Manuel Arnandis, director de Certificación de la Región Levante de SGS.
Formación Profesional para el Empleo: un programa para trabajadores y desempleados
El Grupo Método se complace en anunciar el nuevo programa de Formación Profesional para el Empleo – FPE, un sistema … Leer más
La agudeza visual: definición y características a considerar
La agudeza visual es la capacidad de distinguir y reconocer los detalles de un objeto. Es usual que este parámetro sea confundido con la escala, pero como ya veremos más adelante, el número de dioptrías que tenemos no influye para nada. ¿Quieres aprender más sobre el tema y especializarte en salud ocular? Puedes ampliar tus conocimientos con el Máster en Oftalmología + Auxiliar de Óptica.
Los dispositivos periféricos, elementos mas allá del ordenador
Cuando hablamos de dispositivos periféricos nos referimos a los instrumentos tecnológicos que son externos a una computadora y que sirven para interpretar, almacenar o archivar la información. Si estás interesado en aprender cómo se clasifican estos dispositivos, a continuación, te lo explicamos. Además, si deseas formarte en temas informáticos, Emagister te recomienda la Escuela de Postgrado Industrial con su Máster en Electrónica y Microelectrónica Aplicada.
Qué son y cómo funcionan los tatuajes temporales
Hoy en día, se ha generalizado la tendencia de decorar el cuerpo con distintos elementos que les permitan a las personas lucir una imagen diferente, ya sea por moda, por tradición o por simple gusto. Un ejemplo claro de ello son los tatuajes, diseños en el cuerpo que plasman las ideas o gustos de cada persona.